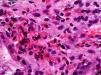

Los trastornos gastrointestinales eosinofílicos primarios comprenden un grupo de entidades clínicas poco frecuentes (exceptuando la esofagitis eosinofílica), con un espectro clínico amplio. Creemos de interés el caso, por los escasos casos publicados a la edad de la paciente, y la gravedad del cuadro en su comienzo.
Paciente de sexo femenino de 15 años que ingresó por cuadro de vómitos y dolor abdominal de 3 meses de evolución, empeorando en las últimas 48h, acompañándose de tetania de las 4 extremidades y dolor retroesternal.
Entre sus antecedentes personales destacaban síntomas digestivos catalogados como posible trastorno alimentario con epigastralgia, que motivó distintas consultas. No ingesta de tóxicos, fármacos ni conductas purgativas. Diagnosticada de infección por Helicobacter pylori con test del aliento y tratada con triple terapia. No alergias ni enfermedades familiares de interés.
A su ingreso, destacaba el regular estado general, vómitos incoercibles, tetania y dolor abdominal, la analítica de inicio mostró hiperglicemia sin cetonemia, leucocitosis discreta con fórmula normal, PCR 0,6mg/dl y VSG 26mm, analítica de deshidratación (urea 55mg/dl y creatinina de 1,5mg/dl) y una alcalosis inicialmente respiratoria y, posteriormente, metabólica. Se procedió a corrección hidroelectrolítica, administración de ondansetrón, omeprazol y diazepam. A las pocas horas empeoramiento clínico-analítico con alcalosis metabólica severa (pH máximo de 7,73; CO3H 38,4mmol/l y EB 17,6) hipopotasemia e hipocloremia que motivó su traslado a la unidad de semicríticos. Precisó de reposición hidroelectrolítica, tratamiento con acetazolamida, bomba de insulina y nutrición parenteral por vía periférica durante 3 días. En el momento de la mejoría clínica, con tolerancia progresiva a fórmula enteral polimérica, se realizó una fibrogastroscopia que mostró lesiones de esofagitis péptica severa grado C desde el tercio medio hasta cardias, con erosiones confluentes sin producir estenosis, estómago normal y estenosis en zona pilórica. Las biopsias informaron de eosinofilia sin presencia de malignidad. Se realizó TC abdominal que descartó masa e informó de engrosamiento de las paredes de píloro y bulbo. A los 7 días y a fin de obtener más información de la zona estenosada se realizó, en otro centro, una ecoendoscopia que mostró imágenes anilladas en esófago medio y distal con estómago normal, y presencia de estenosis en punta bulbar con segunda porción duodenal normal (fig. 1). Las biopsias informaron de fibrosis y edema con más de 60 eosinófilos/CGA en esófago medio y distal, estómago normal (sin Helicobacter pylori ni parásitos), y en punta bulbar, edema y fibrosis en lámina propia y más de 100 eosinófilos/CGA, hallazgos compatibles con gastroenteritis eosinofílica (fig. 2). Se completó posteriormente el estudio descartando causas de eosinofília secundaria.
Con dicho diagnóstico y afectación clínica obstructiva, se inició tratamiento con budesonida oral (9mg/día) y mantenimiento con azatioprina (previa determinación de actividad de la tiopurina metiltransferasa), además de tratamiento con omeprazol, siendo la evolución de la paciente hasta el momento satisfactoria.
Los trastornos gastrointestinales eosinofílicos primarios (TGIEP) abarcan un grupo de enfermedades que se caracterizan por los síntomas que provoca la anormal infiltración de eosinófilos en cualquier parte del tubo digestivo, en ausencia de otras causas secundarias, y que puede afectar a distintas capas. En función de la localización y de su infiltración puede dar diversidad de síntomas, siendo su tratamiento y evolución variable en función de dichos parámetros1. Los últimos estudios en EE.UU. informan de prevalencias2 en gastritis eosinofílica 6,3/100.000, gastroenteritis eosinofílicas 8,4/100.00, colitis 3,3/100.000 y 57/100.000 en esofagitis eosinofílicas (EoE). Se describen a cualquier edad, pero la gran mayoría son en la tercera década y con predominio en las mujeres, siendo en global poco frecuente en edades precoces como nuestro caso.
Entre la patogénesis se describe un mecanismo mixto3, los eosinófilos son activados por la eotaxina y por alérgenos estimulando las células T helper y formando IgE e IL5 con posterior desgranulación de mastocitos liberando histamina y serotonina, y provocando la contracción del músculo liso digestivo. La clínica1,4 variará según el tracto gastrointestinal afectado y las capas. Si la afectación es mucosa, presentan dolor abdominal, diarrea, pérdida de peso y malabsorción. Si afecta muscular, clínica de obstrucción, y si es serosa puede provocar ascitis. En nuestra paciente la afectación de esófago y bulbo, y la infiltración hasta muscular provocó la clínica obstructiva. Nuestra paciente no presentó eosinofilia ni antecedentes de alergia. La eosinofilia se presenta entre el 20-80% de los casos, siendo más común en la forma serosa. La comorbilidad alérgica es muy frecuente hasta una 45% de sujetos. El diagnóstico se confirma por biopsia que nos informará del recuento de eosinófilos por CGA y el número de capas afectadas5.
El tratamiento dependerá de la zona afectada y de su infiltración, en nuestra paciente se desestimó el tratamiento dietético6, y se optó por usar budesonida oral4 y mantenimiento con azatioprina por la posibilidad de recaídas, y omeprazol para tratar su esofagitis péptica.
Consideramos interesante el caso, teniendo en cuenta la edad, la forma grave de comienzo en una adolescente con antecedentes de síntomas digestivos catalogados como posible trastorno alimentario, que nos hizo dudar al inicio de su organicidad, y la afectación severa que obliga a pensar en tratamiento inmunosupresor a largo plazo.